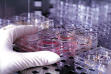

Washington, DC (LifeNews.com) -- Democratic presidential candidate Hillary Clinton said Thursday that one of her first actions if she wins the 2008 election will be reversing President Bush's protections on embryonic stem cell research. Bush has twice vetoed bills that would force taxpayers to fund the research, which requires the destruction of human life.
Washington, DC (LifeNews.com) -- Democratic presidential candidate Hillary Clinton said Thursday that one of her first actions if she wins the 2008 election will be reversing President Bush's protections on embryonic stem cell research. Bush has twice vetoed bills that would force taxpayers to fund the research, which requires the destruction of human life.
Bush also put in place a policy in August 2001 that prevents federal funding of any new embryonic stem cell research and, instead, concentrates most federal money in the area of adult stem cells.
Those are the cells that have shown the most promise in treating patients, as embryonic stem cell research has encountered significant problems such as immune system rejection issues.
Still, she called the limits and protections Bush has instituted a "ban on hope."
"The Bush administration has declared war on science," Clinton claimed in an address to the Carnegie Institution for Science. "When I am president, scientific integrity will not be the exception it will be the rule."
According to an AP report, Clinton also claimed the Bush administration has tied the hands of scientists on both stem cell research as well as issues such as abortion and the morning after pill.
She said she would establish new guidelines preventing political appointees from altering or removing or altering conclusions from government scientists.
"For six and half years under this president, it's been open season on open inquiry," Clinton said. "By ignoring or manipulating science, the Bush administration is letting our economic competitors get an edge in the global economy. I believe we have to change course, and I know America is ready."
She also cited administration officials who have questioned studies showing a link between abortion and breast cancer.
LifeNews.com reported this week on a new study showing how having children helps women reduce their chance of contracting the disease.